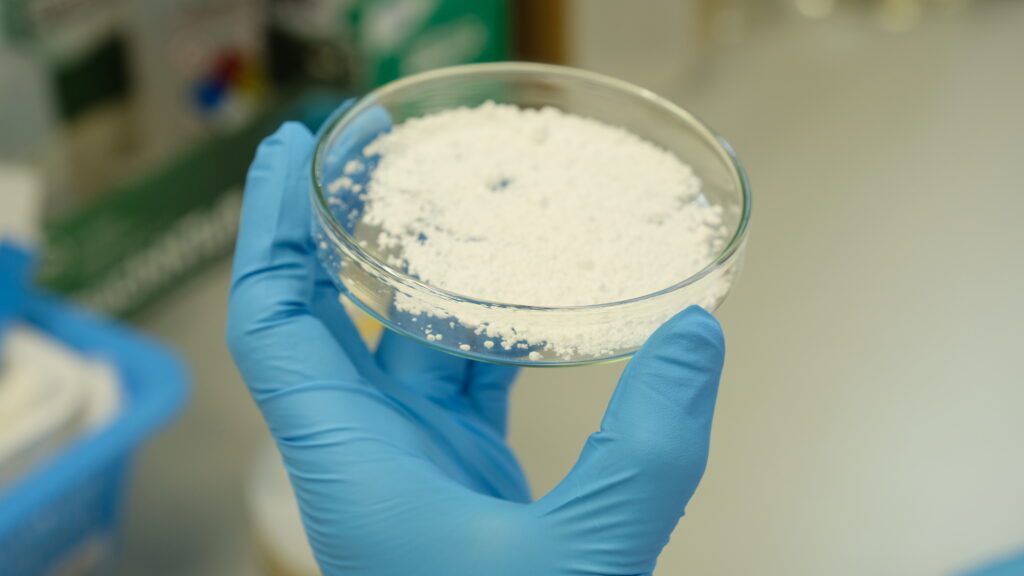

ผนังบ้านเย็น ฝ้าเพดานดูดซับความร้อน เสื้อใส่แล้วเย็น หรือโซลาร์เซลล์โมดูล อาจใช้วัสดุเปลี่ยนสถานะ (PCM) ที่มีสมบัติการดูด-คายความร้อนเป็นส่วนผสมพิเศษ นักวิจัยนาโนเทค (สวทช.) พัฒนาเทคโนโลยีกักเก็บพลังงานความร้อนด้วยวัสดุเปลี่ยนสถานะแคปซูล ชูจุดต่างด้วยการเสริมเทคโนโลยีเคลือบและเทคโนโลยีกักเก็บ ช่วยเพิ่มประสิทธิภาพและความทนทาน ประหยัดพลังงานและต้นทุน จดสิทธิบัตรพร้อมส่งไม้ต่อเอกชน สร้างโอกาสต่อยอดนวัตกรรมไทยสู่อุตสาหกรรมก่อสร้าง ตกแต่งภายใน สิ่งทอ หรือพลังงานทางเลือก
ดร.วรายุทธ สะโจมแสง นักวิจัยจากทีมวิจัยนาโนเทคโนโลยีเพื่อสิ่งเเวดล้อม กลุ่มวิจัยวัสดุผสมและการเคลือบนาโน ศูนย์นาโนเทคโนโลยีแห่งชาติ (นาโนเทค) สำนักงานพัฒนาวิทยาศาสตร์และเทคโนโลยี (สวทช.) กล่าวว่า โครงการวิจัยเรื่อง “เทคโนโลยีกักเก็บพลังงานความร้อนด้วยวัสดุเปลี่ยนสถานะแคปซูล” เป็นการพัฒนาวัสดุเปลี่ยนสถานะ โดยใช้เทคโนโลยีการเคลือบ (Coating technology) และเทคโนโลยีการกักเก็บ (Encapsulation technology) ด้วยวิธีทางเคมี (Chemical method)
“ปัจจุบัน วิกฤตการณ์สภาวะโลกร้อน ก๊าซเรือนกระจก เชื้อเพลิงธรรมชาติที่มีอยู่จำกัด และราคาที่เพิ่มสูงขึ้นอย่างต่อเนื่อง ทำให้มีการคิดค้นเทคโนโลยีและนวัตกรรมต่างๆที่เกี่ยวข้องกับพลังงานทดแทนหรือแนวทางการลดการใช้พลังงาน เพื่อลดการใช้พลังงานจากเชื้อเพลิง” ดร.วรายุทธฯ กล่าว
เทคโนโลยีกักเก็บพลังงานความร้อน (Thermal Energy Storage) เป็นหนึ่งในเทคโนโลยีที่สามารถการกักเก็บพลังงานความร้อนในรูปของการทำความร้อนหรือความเย็นด้วยวัสดุตัวกลาง คือ วัสดุเปลี่ยนสถานะ (Phase Change Materials, PCMs) เรียกสั้นๆ ว่า (PCM) ที่มีคุณสมบัติด้านการกักเก็บความร้อนในรูปของความร้อนแฝง (Latent heat) และทำหน้าที่รักษาอุณหภูมิให้แก่ระบบ เมื่อสภาพแวดล้อมมีอุณหภูมิสูงขึ้นวัสดุ (PCM) จะดูดซับความร้อนจากสภาพแวดล้อมไว้ในตัววัสดุในช่วงของการหลอมละลายจากของแข็งไปเป็นของเหลว เพื่อทำให้อุณหภูมิของระบบคงที่หรือเปลี่ยนแปลงไปเพียงเล็กน้อย ในทางกลับกันเมื่อสภาพแวดล้อมเย็นลง วัสดุ (PCM) จะถ่ายเทพลังงานสู่ระบบเมื่อเปลี่ยนสถานะจากของเหลวเป็นของแข็ง เพื่อรักษาอุณหภูมิให้คงที่ ปรากฎการณ์นี้เองทำให้เกิดกระบวนการดูด-คายความร้อน ซึ่งส่งผลต่ออุณหภูมิภายนอกของสิ่งแวดล้อม
“ด้วยคุณสมบัติในการดูด-คายความร้อนนี้ (PCM) จึงกลายเป็นส่วนประกอบหนึ่งที่ภาคอุตสาหกรรมต่างๆ นำไปใช้เพิ่มประสิทธิภาพ หรือเสริมฟังก์ชั่นการดูดความร้อน ไม่ว่าจะเป็นอุตสาหกรรมก่อสร้างและตกแต่งภายใน ในการทำฝ้า ผนัง หลังคา หรือสีทาบ้านดูดซับความร้อน ทำให้ภายในบ้านเย็น เช่นเดียวกับอุตสาหกรรมสิ่งทอ ที่ใช้ (PCM) ในเส้นใย ทำให้กลายเป็นสิ่งทอที่ดูดซับความร้อน ใส่แล้วเย็น รวมไปถึงโมดูลของแผงโซลาร์เซลล์และแบตเตอรี่ที่ใช้ (PCM) ในการดูดซับความร้อนเพื่อลดอุณหภูมิของโมดูลในการเพิ่มประสิทธิภาพการทำงานและยืดอายุการใช้งานเพิ่มมากขึ้น” ดร.วรายุทธฯ ชี้
อย่างไรก็ดี ปัญหาหนึ่งของวัสดุ (PCM) เกิดจากสมบัติการเปลี่ยนสถานะกลับไปมาระหว่างของแข็งกับของเหลวทำให้การใช้งานวัสดุ (PCM) โดยตรงมีข้อจำกัดหรืออาจทำให้เกิดปัญหาการรั่วไหลและติดไฟได้ รวมไปถึงการถ่ายเทความร้อนของวัสดุ (PCM) มีประสิทธิภาพต่ำเมื่อถูกกักเก็บไว้ในแคปซูลหรือในภาชนะนำส่ง (carrier) เมื่อเปรียบเทียบกับวัสดุ (PCM) บริสุทธิ์ ดังนั้น ดร.วรายุทธฯ และทีมวิจัยนาโนเทคจึงได้พัฒนา (PCM) ในรูปของแคปซูลที่เป็นผงแห้งเพื่อนำมาใช้ในการกักเก็บพลังงานในรูปแบบความร้อนเพื่อแก้ปัญหาดังกล่าวรวมถึงยังสามารถลดปัญหาเรื่องข้อจำกัดในการถ่ายเทความร้อนของวัสดุเปลี่ยนสถานะ เนื่องจากเทคโนโลยีดังกล่าวสามารถเพิ่มพื้นที่ผิวในการถ่ายเทความร้อนของสาร
งานวิจัยนี้จะใช้เทคโนโลยีการเคลือบ (Coating technology) และเทคโนโลยีการกักเก็บ (Encapsulation technology) ด้วยวิธีทางเคมี (Chemical method) ของสาร (PCM) ด้วยแคปซูลวัสดุผสมซิลิกาเป็นหลัก เนื่องจากวัสดุผสมซิลิกาเป็นวัสดุที่ทำหน้าที่เป็นเปลือกห่อหุ้มที่แข็งแรงกว่าเปลือกพอลิเมอร์ นอกจากนี้ ประโยชน์และข้อดีจากวัสดุผสมซิลิกา คือ เสถียรภาพทางอุณหพลศาสตร์ที่ดีเยี่ยม (excellent thermophysical stability) ขณะที่สาร (PCM) ที่ใช้เป็นตัวแทนของ (PCM) สามารถเลือกจากกลุ่มสารอินทรีย์ คือ สารพาราฟิน เช่น n-hexadecane (C16) n-octadecane (C18) หรือกลุ่มที่ไม่ใช่พาราฟิน เช่น กรดไขมันและอนุพันธ์กรดไขมัน แอลกอฮอล์ เป็นต้น หรือสาร (PCM) ทางการค้า ซึ่งสามารถเลือกใช้ให้เหมาะสมกับช่วงอุณหภูมิในประเทศไทยหรือการประยุกต์ใช้งาน
จากการศึกษาของทีมวิจัยพบว่าสามารถเตรียมแคปซูลเพื่อห่อหุ้มวัสดุ (PCM) ได้ 3 แบบ ได้แก่ แคปซูลซิลิกา แคปซูลซิลิกาผสมโลหะออกไซด์ และแคปซูลซิลิกาเคลือบพอลิเมอร์ โดยผ่านปฏิกิริยาอิมัลชั่นพอลิเมอร์ไรเซชัน โดยไม่ต้องใช้ตัวทำละลายอินทรีย์ใช้เพียงน้ำเป็นตัวทำละลาย และยังสามารถเตรียมได้จากการใช้รอบในการกวนที่ต่ำ ทั้งยังทำปฏิกิริยาที่อุณหภูมิไม่สูงมากคือไม่เกิน 100 องศาเซลเซียส สามารถแยกแคปซูลออกด้วยการตกตะกอน ขนาดของอนุภาคของซิลิกาอยู่ในช่วง 0.04-13 ไมโครเมตร มีประสิทธิภาพการห่อหุ้มอยู่ในช่วง 60-100 เปอร์เซ็นต์ มีค่าพลังงานความร้อนในการหลอมเหลว และค่าพลังงานความร้อนในการเกิดผลึก หลังการกักเก็บสาร (PCM) ในซิลิกาแคปซูลทั้ง 3 แบบ สูงกว่าสาร (PCM) บริสุทธิ์ “ที่สำคัญ การกักเก็บวัสดุ (PCM) ในแคปซูลซิลิกาไม่ส่งผลต่อการลดค่าพลังงานความร้อนแฝง ซึ่งเป็นจุดเด่นของงานวิจัยนี้” นักวิจัยนาโนเทค ชี้
ข้อดีของานวิจัยนี้คือ สามารถเตรียมวัสดุ (PCM) ในรูปแคปซูลแบบผงแห้งซึ่งสามารถนำมาประยุกต์ใช้งานได้ง่ายกว่าวัสดุ (PCM) ที่ไม่ได้ห่อหุ้ม เนื่องจากการเปลี่ยนสถานะกลับไปมาซ้ำๆกันหลายพันรอบทำให้เกิดกระบวนการดูด-คายความร้อนเกิดขึ้นภายในแคปซูลที่มีความแข็งแรงไม่เกิดการรั่วไหล โดย (PCM) ในแคปซูลซิลิกาไม่ส่งผลต่อการลดค่าพลังงานความร้อนแฝงของวัสดุ (PCM) ซึ่งเป็นจุดเด่นของงานวิจัยนี้ ทำให้ปริมาณการใช้ PCM ในรูปแคปซูลแบบผงแห้งในปริมาณน้อยลง นอกจากนี้กระบวนการสังเคราะห์ใช้อุณหภูมิไม่สูงมากนัก และการทำให้เป็นผงแห้งใช้กระบวนการตกตะกอนและอบที่อุณหภูมิต่ำทำให้ประหยัดพลังงานและต้นทุน โดยในกระบวนการผลิตสามารถต่อยอดเทคโนโลยีในเชิงพาณิชย์ได้
ดร.วรายุทธฯ ชี้ว่า วัสดุ (PCM) ในรูปแคปซูลแบบผงแห้งสามารถนำมาประยุกต์ใช้ในการควบคุมอุณหภูมิของระบบที่เปลี่ยนแปลงขึ้นและลงอย่างต่อเนื่องให้มีความสมดุล โดยสามารถประยุกต์ใช้ในวัสดุก่อสร้าง (Construction) หรือวัสดุภายในอาคาร สิ่งทอ สีทาบ้าน แบตเตอร์รี่ โซล่าเซลล์ และบรรจุภัณฑ์ เป็นต้น
“แม้วัสดุ (PCM) ในรูปแคปซูลแบบผงแห้งจะมีใช้อยู่แล้วในท้องตลาด แต่วัสดุ (PCM) จากงานวิจัยนี้ ที่ใช้เทคโนโลยีเคลือบและกักเก็บ จะทำให้เพิ่มประสิทธิภาพของวัสดุ (PCM) ให้มากขึ้น แม้จะเพิ่มต้นทุนในส่วนของเปลือกหุ้มที่เป็นซิลิกา แต่สามารถใช้ในปริมาณที่น้อยลงถึง 30-50% ขึ้นอยู่กับการประยุกต์ใช้งาน โดยศักยภาพยังเท่าเดิม ทำให้สามารถแข่งขันได้ในเชิงพาณิชย์ รวมทั้งเอื้อต่อการพัฒนาสูตรผลิตภัณฑ์ต่างๆ ที่ต้องใช้วัสดุ (PCM) เป็นส่วนประกอบในผลิตภัณฑ์” นักวิจัยนาโนเทคชี้
ปัจจุบัน วัสดุ (PCM) ในรูปแคปซูลแบบผงแห้งภายใต้นาโนเทค (สวทช.) ได้จดอนุสิทธิบัตร เลขที่คำขอ 2203001455 วิธีการเตรียมแคปซูลเพื่อห่อหุ้มวัสดุกักเก็บความร้อน เมื่อวันที่ 13 มิถุนายน 2565 และอยู่ระหว่างการแสวงหาผู้ประกอบการเพื่อรับการถ่ายทอดเทคโนโลยี นำนวัตกรรมไทยไปสู่การใช้ประโยชน์อย่างแท้จริง
สุรเชษฐ ศิลานนท์ รายงาน